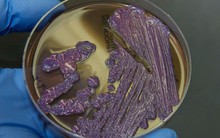
Mọi thông tin về căn bệnh "nhiễm khuẩn ăn thịt người" - Whitmore, đặc biệt là cách phòng ngừa cần lưu ý

© Copyright 2007 - 2026 - Công ty Cổ phần VCCorp.
Tầng 17, 19, 20, 21 Toà nhà Center Building - Hapulico Complex, Số 01, phố Nguyễn Huy Tưởng, phường Thanh Xuân, thành phố Hà Nội
Giấy phép thiết lập trang thông tin điện tử tổng hợp trên mạng số 2216/GP-TTĐT do Sở Thông tin và Truyền thông Hà Nội cấp ngày 10 tháng 4 năm 2019.